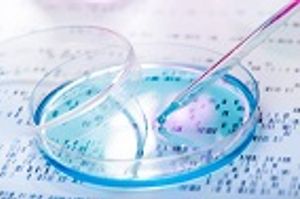

Government agencies and researchers continue to monitor the potentially troubling trend.
Brian P. Dunleavy has been covering health and medical research for more than 25 years, for United Press International and EverydayHealth.com, among other outlets. He is also the former editor of Infectious Disease Special Edition. In addition, he has written on other subjects for Biography.com, History.com, the Village Voice and amNewYork, among others. He holds a master’s degree from the University of Missouri School of Journalism.

Government agencies and researchers continue to monitor the potentially troubling trend.

Findings highlight need for innovative prevention strategies, experts say.

An expert cautions against panic but advises careful study and robust public health response.

Research suggests a political disconnect on the status of global environment that could impact health response during a crisis.

JAMA study reveals use of dexamethasone and others in non-hospitalized patients with mild to moderate illness.

The number of Americans who opt for an additional booster dose of a COVID-19 vaccine may be limited.

Though a valid scientific approach, it may assume benefits incorrectly, researchers warn.

The tactic is seen as a way to ensure supplies of novel drugs in face of resistance crisis.

New policy appears inconsistent and, on the surface, unfair, expert says.

The findings are significant given that a second booster dose may soon be recommended.

Policies keep case counts down even when vaccination rates are low, new analysis finds.

Findings of JAMA Network Open analysis reveal effects of interventions designed to prevent spread.

However, those that do have significant influence—and may have affected vaccination rates and treatment use, research suggests.

Latest update of the bill introduced in the House November, but no word on a potential vote yet.

Study highlights elevated levels of antibody response in those with history of COVID-19.

Findings could help in the development of “screening biomarkers and/or therapeutics,” authors say.

The trend follows predictions that COVID-19 mitigation would lead to case reduction.

The virus was third-leading cause of death nationally, CDC reports.

Former members of the Biden transition team recommend accepting that the virus is here to stay.

A study adds to the growing list of trials assessing convalescent plasma in COVID-19 to yield mixed results.

After increased awareness soon after the emergence of COVID-19, fewer Americans see plight of people of color.

A study's results may have implications for future virus tracking.

The federal agency will provide $22 million in funding to organizations worldwide dedicated to identifying next crisis.

Analysis documents 9% rise in shots distributed after federal officials pushed for vaccination.

Just 39 cases among more than 2.2 million doses administered.

A survey published in JAMA reveals some remain firmly entrenched.

Pilot program benefits those in need most, covering potential costs associated with vaccination.

The World Health Organization's (WHO) newly formed Scientific Advisory Group on the Origins of Novel Pathogens (SAGO) will lay the groundwork for future identification of future disease threats.

Lower rates of COVID-19 vaccination may be due to access, not hesitancy.

Data finds low risk for anaphylaxis, myocarditis, and other potential complications.

Published: March 4th 2016 | Updated:

Published: November 19th 2016 | Updated:

Published: November 22nd 2016 | Updated:
Published: November 23rd 2016 | Updated:

Published: November 26th 2016 | Updated:

Published: November 30th 2016 | Updated: